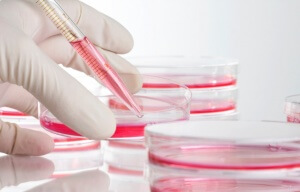
image

Содержание
Согласно статистическим данным, каждый из трех живущих в нашей стране когда-либо подвергался заражению таким неприятным заболеванием как токсоплазмоз. Очень часто заболевший человек даже не догадывается о том, что является носителем токсоплазмоза. Это обусловлено тем, что чаще всего эта болезнь протекает бессимптомно.
Токсоплазмозом: способы заражения
Характеристика токсоплазмоза
Это заболевание инфекционного характера, которое вызывают паразиты. Среди основных возбудителей токсоплазмоза выделяют котов. Их продукты жизнедеятельности проникают в слои почвы, а уже оттуда распространяются на коз, грызунов или коров, которые становятся временными переносчиками. Кроме того, споры возбудителей могут попадать на овощи.
Именно поэтому, не помыв руки, человек может стать носителем токсоплазмоза. Это может произойти после того как он контактировал с животными или же при употреблении в пищу плохо прожаренного мяса или необработанных овощей. Это заболевание начинает развиваться сразу же после того, как в человеческий организм попадает паразит.
Токсоплазмоз может выглядеть неопасным, но если у носителя такого заболевания достаточно ослаблен иммунитет, то последствия могут иметь печальный исход. Особенно это касается женщин, которые находятся в ожидании ребенка. Малыш, находящийся в утробе, может очень серьезно пострадать, потому что возбудители токсоплазмоза с легкостью проникают в плаценту. А это чревато заражением плода, потому что иммунитет ребенка развит не полностью. Такая ситуация может привести к очень тяжелым последствиям, вплоть до гибели не рожденного малыша.
Кроме того, нередки случаи, когда во время заражения токсоплазмозом у женщин, которые находились на ранних сроках беременности происходили самопроизвольные выкидыши, образовывались различные патологии плода, несовместимые с его жизнью или замирал плод.
Так как в нашей стране уровень инфицирования плода в организме будущей матери достаточно велик, врач, который ведет беременность или период планирования предпринимает все необходимые меры, чтобы выявить или исключить такое неприятное заболевание как можно раньше. Беременным женщинам назначается комплексный анализ на инфекции такого рода (ТОРЧ-инфекции). В них входят и анализы на это заболевание.Что касается нормы, то она точно такая же как и у не беременных.
Как реагирует организм на заражение?
Выработка организмом человека антител при заражении
Реакция организма на заражение токсоплазмозом, как и на любое другое заболевание естественна. Он активизирует иммунные защитные силы. Вырабатываются специальные антитела, то есть иммуноглобулины белка относящихся к группам IgG и IgM.
После обнаружения антигена (патогенного микроорганизма) происходит усиленная выработка антител, которые призваны устранить определенную инфекцию. Такие антитела принято называть иммуноглобулинами группы IgG. После того как антиген будет найден, такие антитела начинают связываться с ним, при этом им необходимо разрушить его структуру. Когда развивается такая болезнь, нормой в человеческой крови будет считаться то, обнаружили такую группу иммуноглобулинов или нет.
Все это должно вычисляться на третьи сутки, после того как человек заразился. Они сохраняются у человека всю его жизнь, при этом защищая его от повторного инфицирования. А это значит, что данным заболеванием можно заразиться лишь один раз за всю его жизнь, а после этого защитные силы иммунитета бросают все силы на борьбу с токсоплазмозом и возбудитель заболевания – паразит больше не опасен для человека.
Когда организм заражается токсоплазмозом, ему помогают в борьбе с этим заболеванием и другие представители группы иммуноглобулинов класса IgM.
Здесь нормой антител будет обнаружение иммуноглобулина этой группы после того как паразит уже непосредственно попадет в человеческий организм. Но представители этой группы не смогут справиться с защитой человека от заражения во второй раз, потому что перестанут вырабатываться примерно после полумесяца или спустя месяц с момента, когда произошло инфицирование.
Свойства и норма иммуноглобулина группы IgG
Норма антител
Особенности иммуноглобулинов группы IgG:
- Эти иммуноглобулины прекрасно справляются с нейтрализацией токсинов, которые вырабатывает паразит.
- Являются непосредственными участниками процесса авидности (то есть связываются с имеющимся возбудителем).
- Являются стимуляторами фагоцитоза.
- Проникают сквозь плаценту к плоду и тем самым формируют наличие пассивного иммунитета у него.
Как расшифровываются показатели иммуноглобулина группы IgG? Обычно количественное измерение иммуноглобулина в человеческой крови при подозрении на токсоплазмоз не делают. Нормой в крови принято считать то, обнаружены или же отсутствуют иммуноглобулины.
Чаще всего для анализов применяют условные обозначения “отрицательно” или “положительно”.
Хотя бывают случаи, когда врач принимает решение назначить специальный анализ, называемый количественным. Конечно приводить правильные нормы анализов сложно, так как у каждого лабораторного центра они свои. Это происходит потому что использовались разные химические реактивы во время анализа на выявление наличия заболевания. Норма будет заметно различаться в зависимости от того, в какой лаборатории пациент сдавал кровь.
Больше информации о токсоплазмозе можно узнать из видео.
Характеристика анализа на токсоплазмоз:
- Нормой IgG принято называть показатели, которые будут ниже значения 700 мг/дл. Что же касается положительного результата, то здесь количество иммуноглобулинов должно быть в границе от 700 до 1600 мг/дл (7-16 г/л). Те показатели которые будут гораздо ниже, принято относить к отрицательным.
- При использовании единиц измерения с другим обозначением принято указывать нормы показателей иммуноглобулина группы IgG, которые будут больше значения 12 Ед/мл. В этом случае их принимают за положительный результат.
- Если же норма показателей иммуноглобулинов IgG будет ниже значения 9 Ед/мл, то ее принимают за отрицательный результат. В этом случае пациентам обычно назначают дополнительные исследования, так как такие показатели нельзя назвать совершенно точными и они вызывают сомнение.
- Совершенно неважно, какими именно единицами измерения обозначены показатели. В любом случае результат будет расшифровываться одинаково. Нормой принято считать те результаты анализов, когда в человеческой крови отсутствуют антитела группы IgM и присутствуют IgG.
Если в материале для исследований есть наличие иммуноглобулинов группы IgG, то это означает, что в организме человека уже присутствовал паразит, который является возбудителем этого заболевания. А из этого следует, что во второй раз человек уже не заразится такой болезнью. Хотя иногда такие показатели могут указывать на то, что пациент недавно первично заразился.
Чтобы точно узнать, что же означают такие данные, необходимо уделить внимание тому, какие показатели у иммуноглобулинов IgM, которые появляются у человека лишь в то время, когда происходит острая фаза заболевания.
Именно по этой причине присутствие таких антител говорит о том, что пациент подвергся первичному заражению и плод подвергается серьезной опасности. Когда происходит такая ситуация, врачу приходится ставить серьезный диагноз – токсоплазмоз. Если результаты проведенных анализов показывают, что иммуноглобулин группы IgG отсутствует в человеческом организме, необходимо уделить огромное внимание профилактике такого заболевания.
Нужно предпринимать все необходимые меры, чтобы не заразиться токсоплазмозом во время беременности. Такие результаты могут показывать, что в организме нет защитных антител от этой болезни.
Заметили ошибку? Выделите ее и нажмите Ctrl+Enter, чтобы сообщить нам.